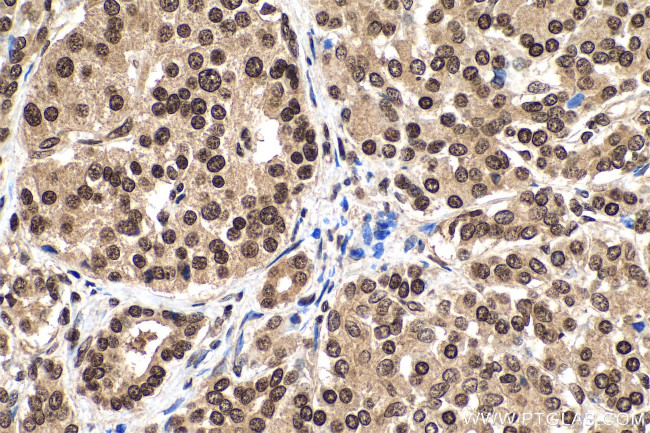
m7G Antibody in Immunohistochemistry (Paraffin) (IHC (P))

Search
Proteintech
m7G Monoclonal Antibody (2C3E10)
{{$productOrderCtrl.translations['antibody.pdp.commerceCard.promotion.promotions']}}
{{$productOrderCtrl.translations['antibody.pdp.commerceCard.promotion.viewpromo']}}
{{$productOrderCtrl.translations['antibody.pdp.commerceCard.promotion.promocode']}}: {{promo.promoCode}} {{promo.promoTitle}} {{promo.promoDescription}}. {{$productOrderCtrl.translations['antibody.pdp.commerceCard.promotion.learnmore']}}
产品信息
68302-1-IG
种属反应
宿主/亚型
分类
类型
克隆号
抗原
偶联物
形式
纯化类型
保存液
内含物
保存条件
运输条件
靶标信息
7-Methylguanosine is a modified nucleoside consisting of a guanine base linked to a ribose sugar with a methyl group attached to the 7th position of the guanine. It is commonly found in the 5' cap structure of eukaryotic mRNA molecules. The main function of 7-methylguanosine is to protect the mRNA from degradation and assist in its translation. It plays a crucial role in facilitating the binding of the ribosome to the mRNA during protein synthesis. The location of 7-methylguanosine is primarily at the 5' end of mRNA molecules, where it serves as a recognition signal for various cellular processes involved in mRNA processing, export, and translation.
仅用于科研。不用于诊断过程。未经明确授权不得转售。
篇参考文献 (0)
生物信息学
蛋白别名: m7G